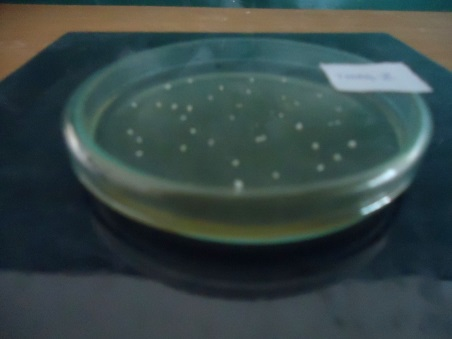
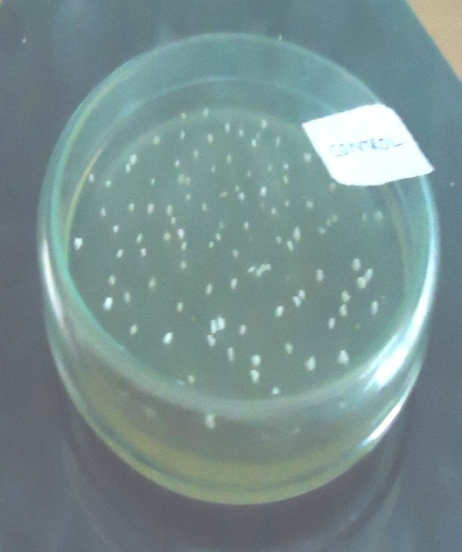
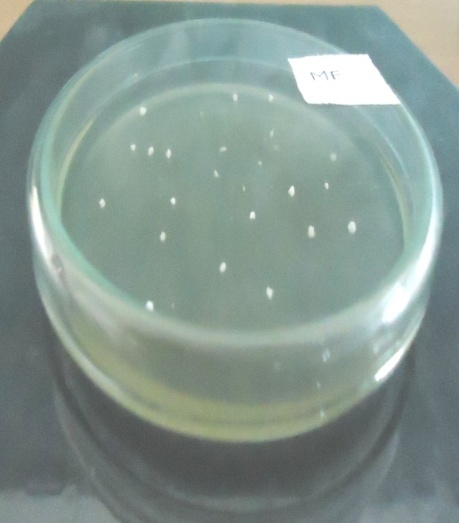
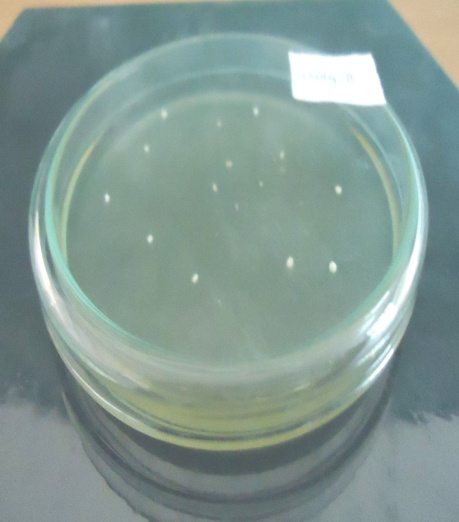
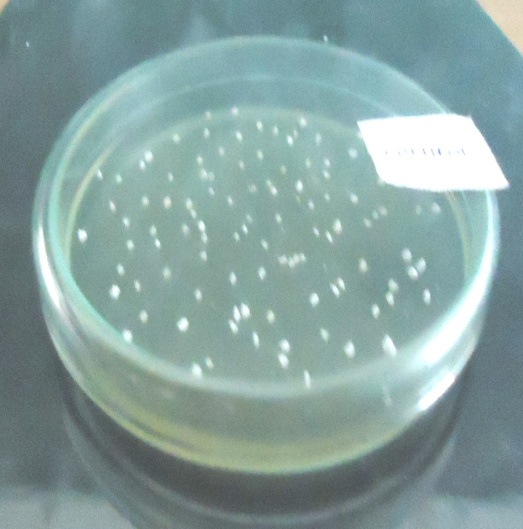

Int J App Pharm, Vol 11, Issue 6, 2019, 78-85Original Article
FORMULATION AND EVALUATION OF TERBINAFINE HYDROCHLORIDE MICROSPONGE GEL
VEDAVATHI THAVVA1, SRINIVASA RAO BARATAM2
1CMR College of Pharmacy, Kandlakoya (V), Medchal Road, Hyderabad, Telangana, India 501401, 2St. Ann’s College of Pharmacy, Andhra University, Cantonment, Vizianagaram, Andhra Pradesh, India 535003
Email: vedavathi.thavva@gmail.com
Received: 10 Feb 2019, Revised and Accepted: 02 Sep 2019
ABSTRACT
Objective: The purpose of the present research work was to formulate and evaluate Terbinafine hydrochloride microsponges using quasi emulsion solvent diffusion technique and microsponge gel by using carbopol for controlled release of the drug and consequently avoiding its side effects.
Methods: Microsponges containing Terbinafine hydrochloride were obtained successfully with six different drugs: polymer ratios. The formulations were studied for particle size, physical characterization, and in vitro release.
Results: A selected THCI microsponge (MS IV) due to its better results when compared to other microsponge formulations were incorporated in different concentrations of carbopol and formulated as gels and evaluated for its pH, viscosity, spreadability, drug content, in vitro release, antifungal activity and in vivo studies. Among the four microsponge gel formulations, THMG II showed better results like pH 6.2, viscosity 3960 cps, spreadability 18.1 g cm/s, drug content of 87.6% and drug release showed fickian release pattern. The antifungal studies showed a zone of inhibition with 15.8 mm when compared to the pure drug, 19.2 mm, marketed formulation 16.0 mm and also showed better antifungal activity on fungal induced guinea pig skin when compared with control.
Conclusion: In this study, we found that the controlled release of terbinafine hydrochloride from the microsponge gel reduced side effects and remarkably decreased gel application for fungal treatment.
Keywords: Antifungal, Gel, Microsponges, Terbinafine Hydrochloride
© 2019 The Authors. Published by Innovare Academic Sciences Pvt Ltd. This is an open-access article under the CC BY license (http://creativecommons.org/licenses/by/4.0/)
DOI: http://dx.doi.org/10.22159/ijap.2019v11i6.32502
INTRODUCTION
Microsponges are porous, polymeric microspheres having a myriad of interconnected voids of particle size ranging from 5-150 µm. Microsponge Drug Delivery System (MDS) is a unique technology that provides controlled release of active ingredients [1-3]. They are mostly used for prolonged topical administration. Microsponges are designed to deliver pharmaceutical active ingredient efficiently at the minimum dose and also to enhance stability, reduce side effects and modify drug release profiles [4-7]. An MDS is highly cross-linked that acquire the flexibility to entrap a wide variety of active ingredients such as emollients, fragrances, sunscreens, essential oils, anti-infective, anti-fungal and anti-inflammatory agents etc and are used as a topical carrier system. They can be incorporated into a conventional dosage form such as creams, lotions, gels, ointments, tablets, and powders and share a broad package of benefits and thus provides formulation flexibility [8-10].
The incidence of mycoses,, especially superficial fungal infections is increasing and according to a recent report, more than 25% of the world's population is affected [11, 12], disease progression is more rapid and severity increased in patients with compromised immune function [13].
Terbinafine hydrochloride (THCI) is a broad-spectrum antifungal activity against a wide variety of fungi [14-16]. It is an ally amine antifungal used in the treatment of jock itch and athletes foot. It is highly lipophilic in nature and tends to accumulate in skin and nails when applied topically and cause side effects like rash, irritation etc. Because of the size and porous polymeric structure of microsponges, they slowly release the active ingredient, thereby prevent excess build up in epidermis and dermis and reduce side effects. Terbinafine hydrochloride (THCI) has Pharmacokinetic interactions with drugs that are substrates for CYP2D6 (e. g., tricyclic antidepressants, β-blockers, selective serotonin reuptake inhibitors [SSRIs], monoamine oxidase [MAO] inhibitors) [17, 18].
The aim of the present investigation was to design novel terbinafine hydrochloride microsponges (I-VI) with six different ratios of the drug: polymer, which acts as carriers for topical delivery of THCI. This investigation consisted of preparation, and evaluation of terbinafine hydrochloride microsponge gels (THMG) (I-IV), prepared by using the selected microsponges and different concentrations of carbopol, to obtain the cosmetically acceptable product for controlled drug release, prolonged duration of action and less side effects.
MATERIALS AND METHODS
Materials
Terbinafine hydrochloride (THCI) was supplied as a gift sample from MSN Laboratories Ltd, Bollaram, India, Ethyl Cellulose, Polyvinyl alcohol, and Dichloromethane was purchased from SD Fine Chem Limited, Mumbai. Carbopol 940, Triethanolamine was purchased from Qualikems Fine Chem Pvt. Limited, Vadodara. Ethanol was purchased from Jiangsu Huax. International Trade Co. Ltd, China. PEG 400 purchased from Otto biochemical reagents, Mumbai.
Preparation and characterization of THCl microsponges
Preparation of the microsponges
The microsponges containing Terbinafine hydrochloride (THCI) were prepared by quasi emulsion solvent diffusion method [19] using different drug: polymer ratios as shown in table 1. The inner phase Ethylcellulose was dissolved in dichloromethane and then added the drug to the solution under ultrasonication at 35 °C. The inner phase is then poured into the PVA solution in water. The resultant mixture was stirred at speed of 3000 rpm for 60 min and filtered to separate the microsponges. The microsponges were dried in a hot air oven at 40 °C for 12 h and weighed to determine the yield [20].
Characterization of THCl microsponges
Fourier transforms infrared (FTIR) analysis
FT-IR spectra of finely powdered pure terbinafine hydrochloride, Ethylcellulose as well as the THCl microsponge formulation were recorded on an FT-IR spectrophotometer (Shimadzu, Kyoto, Japan) by potassium bromide (KBr) disk pellet method [21].
Scanning electron microscopy (SEM)
The morphology of microsponges was examined using a scanning electron microscope (GEOL 5400, USA) operating at 20 kV. Dried microspheres were coated with gold-palladium alloy for 45s under an argon atmosphere before observation. SEM photograph was recorded at a magnification of ×500 and 1500.
Table 1: Composition of the prepared THCl microsponge systems
| Constituents | Microsponges formulation | |||||
| MS I | MS II | MS III | MS IV | MS V | MS VI | |
| Terbinafine hydrochloride (g) | 1 | 1 | 1 | 1 | 1 | 1 |
| Ethyl cellulose (g) | 0.1 | 0.2 | 0.3 | 0.4 | 0.5 | 0.6 |
| Dichloromethane (ml) | 5 | 5 | 5 | 5 | 5 | 5 |
| PVA (g) | 0.05 | 0.05 | 0.05 | 0.05 | 0.05 | 0.05 |
| Distilled water (ml) | 200 | 200 | 200 | 200 | 200 | 200 |
Particle size studies
Particle size analyses were performed on microsponge by laser light scattering technique using Mastersizer 2000 (Malvern Instruments Ltd., Worcestershire, UK). The result is the average of the three analyses. The values (D50) were expressed for all formulations as a mean size range [22].
Determination of loading efficiency
The drug content in the microsponge was determined spectrophotometrically (λ max, 274 nm). A sample of terbinafine hydrochloride microsponges (10 mg) was dissolved in 100 ml of phosphate buffer, freshly prepared (pH 7.4). The drug content was calculated from the calibration curve and expressed as loading efficiency [23].

Determination of production yield
The production yield of the microsponge was determined by calculating accurately the initial weight of the raw materials and the last weight of the microsponge obtained [23].

Dissolution behavior of microsponges
The drug release tests of the microsponges were carried out for 8 h at 100 rpm by the paddle method. The temperature of the dissolution medium was controlled at 32±1 °C. The microsponges equivalent to 50 mg of THCI were weighed. The dissolution medium was 150 ml of phosphate buffer (pH 7.4) to keep the sink condition for the drug. Three milliliters of the dissolution medium were sampled at certain intervals (0.5-8 h) and a fresh dissolution medium was simultaneously replaced in the apparatus to keep the volume constant. The withdrawn samples were filtered with a membrane filter (0.45 μm) and the filtrate was assayed spectrophotometrically at 274 nm.
Preparation and characterization of terbinafine HCl microsponge gel
Preparation of terbinafine hydrochloride microsponge gel (THMG)
Four gels were prepared by using the best microsponge formulation and different concentrations of carbopol 940 as shown in table 2. An accurately weighed amount of carbopol 940 was taken and dissolved in water using the propeller. In another beaker, microsponges containing Terbinafine hydrochloride (free or entrapped, equivalent to 0.1%w/v) drug dissolved in ethanol and added to carbopol solution by stirring, followed by addition of PEG 400. Neutralize the carbopol solution by slowly adding triethanolamine solution with constant stirring until the gel is formed. The pH of the final gel formed was determined [24].
Characterization of Terbinafine HCl microsponge gel
Physical parameters of THMG
Four gel formulations containing terbinafine hydrochloride microsponges were characterized for pH using pH meter, viscosity using a Brookfield digital viscometer (Model DV-III+Rheometer), spreadability and drug content [25-27].
Table 2: Formulation of gels containing THCI microsponges
| Ingredients | THMG-I | THMG-2 | THMG-3 | THMG-4 |
| Microsponge Eqv to THCl 0.1% w/v | 1 | 1 | 1 | 1 |
| Carbopol 940(g) | 0.25 | 0.35 | 0.45 | 0.55 |
| Ethanol(ml) | 15 | 15 | 15 | 15 |
| PEG 400(g) | 15 | 15 | 15 | 15 |
| Triethanolamine(g) | 5 | 5 | 5 | 5 |
| Water up to (ml) | 100 | 100 | 100 | 100 |
In vitro release study
The in vitro release of THMG formulations was studied by membrane diffusion technique using a cellophane membrane. The dissolution medium is pH7.4 phosphate buffer, freshly prepared. Cellophane membrane previously soaked overnight in the dissolution medium was tied to one end of a specifically designed glass cylinder (open at both ends). 1g of the formulation (equivalent to 1000 mg of Terbinafine hydrochloride) was accurately placed into this assembly. The cylinder was attached to stand and suspended in 200 ml of dissolution medium maintained at 37±1 °C, the membrane just touching the receptor medium surface. The dissolution medium was stirred at 100 rpm speed using Teflon coated magnetic bead. Aliquots, each of 5 ml volume were withdrawn periodically at a predetermined time interval of 15, 30, 60, 120, 180, 240, 300, 360 min and replaced by an equal volume of the receptor medium to maintain sink conditions. The aliquots were suitably diluted with the receptor medium and analyzed by UV-visible spectrophotometer at 274 nm using neutralized phthalate buffer as blank [28].
Several mathematical models attempt to correlate dissolution profiles with the mechanisms of drug release from the drug delivery system [29, 30]. In this work, zero-order first order, Higuchi and Korsmeyer-Peppas models were applied to analyze the release profile of THCl from the prepared microsponge gels [31-35].
Antimicrobial activity
This was determined by sabouraud dextrose medium employing “cup plate technique” using previously sterilized Petri dish. A Solution of the prepared gel formulation, marketed gel and pure terbinafine hydrochloride as a standard 1 mg/ml was poured into cups bored of size 8 mm into wells of sabouraud dextrose plate previously seeded with test organism (Candida albicans Procured from MTCC, Chandigarh, Acc. No.183). After allowing diffusion of solution for 2 h, the plates were incubated at 27 °C for 48 h. The zone of inhibition measured around each cup was compared with that of marketed gel and standard [36].
In vivo study
Male guinea pigs (250-350 g) were used. The hair was removed from their flanks with an electrical clipper. The area of skin (20 mm diameter) on each flank was scarified with coarse sandpaper. Scarified skin was infected with few drops of the culture of Candida albicans. Infected guinea pigs were housed individually in wire bottom cages and were provided food and water ad libitum. The fungal infection was induced on the guinea pig for the first 3 d, on the 4th day; the skin of guinea pig was scraped and was cultivated in sabouraud dextrose agar media plates. The inoculated plates were incubated at 27 °C for 48 h. The colonies were measured after incubation. On the 4th day, treatment was initiated by topical application to the infected sites with gel formulation for another 4 d. On the 8th and 11th day skin was again scraped and cultured on sabouraud dextrose agar plate respectively and further treatment was done. The inoculated plates were incubated at 27 °C for 48 h and examined for growth of colonies [36,37].
RESULTS AND DISCUSSION
In the quasi-emulsion solvent diffusion method, the formation of microsponges could be by the rapid diffusion of dichloromethane (A good solvent for the polymer and drug) into the aqueous medium, might reduce the solubility of the polymer in the droplets, since the polymer was insoluble in water. The instant mixing of dichloromethane and water at the interface of the droplets induced precipitation of the polymer, thus forming a shell enclosing the dichloromethane and the dissolved drug. The finely dispersed droplets of the polymer solution of the drug were solidified in the aqueous phase via diffusion of the solvent [38].
FTIR spectra of pure Terbinafine hydrochloride, Ethylcellulose and mixture were shown in fig. 1, 2 and 3. Fundamental peaks of terbinafine It clearly indicates that the FTIR spectra of pure Terbinafine hydrochloride were compatible with Ethylcellulose polymer.

Fig. 1: FTIR spectra of Terbinafine hydrochloride

Fig. 2: FTIR spectra of Ethylcellulose

Fig. 3: FTIR spectra of microsponge formulation
The scanning electron photograph of the microsponge is shown in fig. 4. It was observed by SEM analysis that the microsponges were finely spherical and uniform. Microscopy studies showed that THCI microsponges contained pores. The pores were induced by the diffusion of the solvent from the surface of the microparticles. The appearance of the particles was such that they were termed microsponges.

Fig. 4: SEM of THCI loaded microsponge formulation
Changing drug: polymer ratio has a considerable effect on the size of the prepared THCI microsponge. Increasing the polymer fraction significantly increased the particle size as shown in table 3. This could probably be due to increasing the amount of polymer available per microsponge, hence larger particle size was obtained.
The loading efficiency of terbinafine hydrochloride microsponge formulations is given in table 3. The loading efficiency calculated for all microsponges ranged from 85.5 to 92 %. The highest loading efficiency was found for the MS IV formulation, where a greater amount of drug was encapsulated. The production yield of Terbinafine hydrochloride microsponge formulations is given in table 3. Production yield calculated for all microsponges ranged from 65.75 to 78.66 %. From the production yields of Terbinafine hydrochloride microsponge formulations, it was indicated that increasing the drug: polymer ratio to some extent increased the production yield.
Table 3: Particle size, production yield and loading efficiency of THCI microsponges
| Formulation code | Particle size (µm) | Production yield (%) | Drug loading (%) |
| MS I | 43.8±0.15 | 65.75±0.45 | 85.5±0.64 |
| MS II | 44.8±0.34 | 67.33±0.54 | 86.5±0.32 |
| MS III | 45.6±0.65 | 68±0.76 | 90.5±0.54 |
| MS IV | 48.2±0.54 | 78.6±0.65 | 92±0.45 |
| MS V | 46.2±0.32 | 72.5±0.78 | 91.5±0.32 |
| MS VI | 48.5±0.43 | 70.57±0.24 | 90±0.45 |
(mean±SD, n=3)
The THCI release from the microsponge formulations is shown in fig. 5 and table 4. The fig. shows that, generally, the release rate was high during the first two hours then the microsponges were able to sustain the release of THCI for more than 8 h in most formulations was shown in table 4. THCI release kinetics of microsponges on the basis of the highest r2 can be explained by Higuchi diffusion mode (data not shown). Based on the above characterization MS IV (having acceptable yield, particle size, high entrapment efficiency, and slow-release profile) was chosen as candidate formula and was subjected further in gel formulations.

Fig. 5: Release profile of THCI microsponge formulations (Values are expressed as mean±SD, n=3)
Table 4: In vitro drug release studies of THCI microsponge formulations
| Time (h) | Formulation code |
| MS-1 | |
| 0 | 0 |
| 1 | 25.05±0.25 |
| 2 | 28.51±0.21 |
| 3 | 31.31±0.32 |
| 4 | 37.16±0.63 |
| 5 | 40.6±0.54 |
| 6 | 53.01±0.43 |
| 7 | 55.1±0.76 |
| 8 | 58.83±0.96 |
(mean±SD, n=3)
The four gel formulations showed physical characteristics like spreadability, viscosity, pH and drug content, as given in table 5. The drug content of the formulations showed that the drug was uniformly distributed in the gels.
Table 5: Spreadability, viscosity, pH and drug content of the formulated gels
| Formulation code | Spreadability (g. cm/s) | Viscosity(cps) | pH | Drug content (%) |
| THMG-I | 17.62±0.13 | 3860±5 | 6.7±0.3 | 82.8±0.28 |
| THMG-II | 18.1±0.24 | 3960±4 | 6.2±0.2 | 87.6±0.87 |
| THMG-III | 16.53±0.26 | 4005±6 | 6.8±0.4 | 85.2±0.71 |
| THMG-IV | 15.8±0.18 | 4206±2 | 6.4±0.5 | 83.6±0.57 |
| Marketed Formulation | 18.3±0.33 | 3963±4 | 6.2±0.4 | 88.9±0.85 |
(mean±SD, n=3)
The in vitro release profile of four THCI microsponges gels was observed for 6 h and was depicted in fig. 6 and table 6. The total amount of drug release was 75.63%, 79.4%, 69.4%, 64.9% and 84.8% observed at different time intervals for a period of 6 h for THMG I-IV and Marketed formulation (MF) respectively. The gel formulation (THMG II) showed the best release i.e. total amount of drug release was 79.4 %. From the logarithmic plot of the release data log Q versus log t of TMHG II, the diffusion exponent (n) and the kinetic constant (k) have been calculated, as shown in table 5. The results showed that n value of microsponges loaded gel is less than 0.5. This indicates that the mechanism of drug release is Fickian diffusion, and is controlled by the porosity of the microsponges.

Fig. 6: In vitro release profile of terbinafine hydrochloride from gel formulation (Values are expressed as mean±SD, n=3)
Table 6: In vitro drug release studies of gel formulations
| Time (min) | Formulation code | ||||
| MF | THMG-1 | THMG-2 | THMG-3 | THMG-4 | |
| 0 | 0 | 0 | 0 | 0 | 0 |
| 15 | 18.3±0.29 | 17.5±0.23 | 17.6±0.31 | 18.5±0.54 | 19.3±0.45 |
| 30 | 25.9±0.45 | 18.9±0.75 | 23.6±0.54 | 26.6±0.36 | 24.3±0.25 |
| 60 | 32.1±0.76 | 28.4±0.85 | 29.6±0.43 | 31.6±0.76 | 28.6±0.73 |
| 90 | 40.2±0.34 | 32.49±0.75 | 38.63±0.41 | 36.8±0.64 | 36.3±0.64 |
| 180 | 55.3±0.65 | 46.55±0.53 | 47.3±0.74 | 43.3±0.83 | 42.6±0.87 |
| 240 | 65.2±0.39 | 53.21±0.88 | 58.8±0.65 | 55.6±0.67 | 49.8±0.36 |
| 300 | 71.13±0.76 | 64.21±0.59 | 69.3±0.27 | 63.3±0.87 | 55.8±0.64 |
| 360 | 84.8±0.56 | 75.63±0.61 | 79.4±0.29 | 69.4±0.56 | 64.9±0.77 |
(mean±SD, n=3)
Table 5: Kinetic treatment of the release data of THCI from microsponge loaded carbopol gel (THMG II)
| Release order | Correlation coefficient |
| Zero-order | 0.945 |
| First-order | 0.930 |
| Diffusion | 0.978 |
| Peppas | 0.842 |
Antifungal activities for gels are shown in table 6. Formulation THMG II showed a zone of inhibition 15.8 mm in comparison with the marketed formulation and pure drug with 16.0 and 19.2 mm respectively.
Table 6: Results of the antifungal study
| Formulation | Zone of Inhibition |
| THMG-I | 14.3±0.16 |
| THMG-II | 15.8±0.23 |
| THMG-III | 13.5±0.45 |
| THMG-IV | 12.5±0.47 |
| MF | 16±0.65 |
| Pure drug | 19.2±0.25 |
| Control | ------ |
(mean±SD, n=3)
The results of the in vivo antifungal activity on guinea pig skin are shown in table 7. The fungal infection was induced on the guinea pig for the first 3 d, on the 4th day, the skin of guinea pig was scraped and was cultivated in sabouraud dextrose agar media plates and colony count was observed more than 50 for formulation THMG I-IV, MF and control respectively.
The treatment of the gel formulation was started from 4th day applying for the next 4 d and studied with the effectiveness of gel on fungal inhibition. After 8th day the skin of the guinea pig was again scraped and checked for the growth of the colony in sabouraud dextrose agar plate. Colony count was observed 40, 30, 38, 35, 32 and more than 50 for formulation THMG I-IV, MF, and control, respectively. Similarly, on the 11th day, the skin of guinea pig was again scraped and checked for the growth of the colony in sabouraud dextrose agar plate. Colony count was observed 21, 13,19,15,12 and more than 50 for formulation THMG I-IV, MF, and control, respectively.
Antifungal study and in vivo study results showed that formulation THMG II showed good inhibition of fungal infection in comparison with the marketed formulation and control. These studies were carried out in the Pharmacology laboratories of the College of Pharmaceutical Sciences, Andhra University which is approved by the institutional animal ethics committee and CPCSEA (Regd. No. 516-01/A/CPCSEA) for experimentation on animals.
Table 7: In vivo antifungal study on the guinea pig
| Formulation | Colonies | ||
| 4th day | 8th day | 11th day | |
| THMG-I | >50 | 40 | 21 |
| THMG-II | >50 | 30 | 12 |
| THMG-III | >50 | 38 | 19 |
| THMG-IV | >50 | 35 | 15 |
| MF | >50 | 32 | 13 |
| Control | >50 | >50 | >50 |

8th day inhibition of colony after application of formulated gel THMG-II, marketed formulation and control.

11th day inhibition of colony after application of formulated gel THMG-I, marketed formulation and control.
Fig. 7: In vivo antifungal study on the guinea pig skin
CONCLUSION
Microsponge based delivery system has been developed using quasi emulsion solvent diffusion method to provide a sustained release medication for topical delivery of Terbinafine Hydrochloride. The drug entrapment efficiency and the size of the prepared microsponges were affected by the drug: polymer ratio. Microsponge formulation MS IV which showed good results incorporated in different concentrations of carbopol and formulated as gels THMG I-IV. Among the four gels, THMG II showed better antifungal activity. A fickian diffusion which is controlled by the porosity of the microsponges is the mechanism of the drug release from the carbopol gel loaded with the selected microsponge formulation. As the gel has sustained-release characteristics the side effects have been minimized.
ACKNOWLEDGMENT
We, authors, wish to thank all those who helped us to do this research work. Thankful to MSN Laboratories Ltd, Bollaram, India for providing gift sample of Terbinafine hydrochloride drug and Principal, CMR College of Pharmacy, Hyderabad, University College of Pharmaceuticals Sciences, Andhra University, Visakhapatnam, St. Ann's College of Pharmacy, Vizianagaram India for providing necessary facilities.
AUTHORS CONTRIBUTIONS
All the authors have contributed equally
CONFLICTS OF INTERESTS
All the authors hereby declare that there are no conflicts of interest
REFERENCES
B MP, G KS, S HV, Yogita S. Recent advances in microsponges drug delivery system. J Crit Rev 2016;3:9-16.
Jain NK. Advances in controlled and novel drug delivery. New Delhi: CBS Publishers and Distibuters; 2003. p. 89-91.
Kydonius AF. Controlled release technologies: methods, theory and application, boca raton. CRC; 1980. p. 21-49.
Nacht S, Katz M. The microsponge: a programmable delivery system. In: Osborne, DW, Aman AH. Topical drug delivery formulations. New York: Marcel Dekker; 1990. p. 299-325.
Embil K, Ntcht S. The microsponge delivery system (MDS): a topical delivery system with reduced irritancy incorporating multiple triggering mechanisms for release of actives. J Microencapsul 1994;13:575-88.
Jain V, Singh R. Dicyclomine loaded Eudragit-based microsponge with potential for colonic delivery: preparation and characterization. Trop J Pharm Res 2010;9:67-72.
Jelvehgari M, Siahi Shadbad M, Azarmi S, Martin GP, Nokhodchi A. The microsponge delivery system of benzoyl peroxide: preparation, characterization and release studies. Int J Pharm 2006;308:124-32.
Kim W, Hwang S, Park J, Park H. Preparation and characterization of drug-loaded polymethacrylate microspheres by an emulsion solvent evaporation method. J Microencapsul 2002;6:811-22.
Kawashima Y, Niwa T, Hand T, Takeuchi H, Iwamoto T. Control of prolonged drug release and compression properties of ibuprofen microspheres with acrylic polymer by changing their intra-particle porosity. Chem Pharm Bull 1992;40:196-201.
Dashora K, Saraf S. Effect of processing variable in micro particulate system of nimesulide. Chinese J Pharm 2006;58:67-74.
Ameen M. Epidemiology of superficial fungal infections. Clin Dermatol 2010;28:197–201.
Hay R. Superficial fungal infections. Medicine 2009;37:610–2.
Ramos-e-Silva M, Lima CMO, Schechtman RC, Trope BM, Carneiro S. Superficial mycoses in immune depressed patients (AIDS). Clin Dermatol 2010;28:217–25.
Alberti I, Kalia YN, Naik A, Bonny JD, Guy RH. In vivo assessment of enhanced topical delivery of terbinafine to human stratum corneum. J Controlled Release 2001;71: 319–27.
Balfour JA, Faulds D. Terbinafine: a review of its pharmacodynamic and pharmacokinetic properties and therapeutic potential in superficial mycoses. Drugs 1992;43:259–84.
Kazakov PV, Golosov SN. A simple method for obtaining terbiınafine hydrochloride. Pharm Chem J 2004;38:34–6.
Novartis. Lamisil (terbinafine hydrochloride) tablets prescribing information. East Hanover. NJ; 2005.
Novartis. Lamisil (terbinafine) oral granules prescribing information. East Hanover. NJ; 2007.
Jadhav N, Patel V, Mungekar S, Bhamare G, Karpe M, Kadams V. Microsponge delivery system: an updated review, current status and future prospects. J Sci Ind Res 2013;2:1097-110.
Thireesha B, Prasad AR, Peter PLH. Formulation and evaluation of lornoxicam microsponges using eudragit rs 100 and eudragit rspo. Asian J Pharm Clin Res 2018;11:217-21.
Yadav V, Jadhav P, Dombe S, Bodhe A, Alunkhe P. Formulation and evaluation of microsponge gel for topical delivery of antifungal drug. Int J Appl Pharm 2007;9:30-7.
Martin A, Swarbrick J, Cammarata AX. In: Physical pharmacy-physical chemical principles in pharmaceutical sciences. 3rd Ed. Philadelphia: Willey; 1991. p. 527.
Dsouza JI, More HN. Topical anti-inflammatory gels of fluocinolone acetonide entrapped in eudragit based microsponge delivery system. Res J Pharm Tech 2008;1:502-6.
Saboji JK, Manvi FV, Gadad AP, Patel BD. Formulation and evaluation of ketocnazole microsponge gel by quasi emulsion solvent diffusion. J Cell Tissue Res 2011;11:2691-6.
Loganathan V, Manimaran S, Sulaiman A, Reddy MVS, Senthil BK, Rajaseskar A. Synthesis and anti-cancer activity of some L -cystine derivatives. Indian J Pharm Sci 2001;63:200-4.
Rao NGR, Rao KP, Muthalik S. Development and evaluation of carbamazepine fast dissolving tablets prepared with a complex by direct compression technique. Asian J Pharma 2009;3:125-34.
Kedor Hackmann ERM, Santoro, MIRM, Singh AK, Peraro AC. First-derivative ultraviolet spectrophotometric and high-performance liquid chromatographic determination of ketoconazole in pharmaceutical emulsions. Brazilian J Pharm Sci 2006;42:91-8.
Doijad RC, Manvi FV, Rao SNM, Alase P. Sustained ophthalmic delivery of gatifloxacin from In situ gelling system. Indian J Pharm Sci 2006;68:814-8.
Costa P, Sousa Lobo JM. Modeling and comparison of dissolution profiles. Eur J Pharm Sci 2001;13:123–33.
Husson I, Leclerc B, Spenlehauer G, Veillard M, Couarraze G. Modeling of drug release from pellets coated with an insoluble polymeric membrane. J Controlled Release 1991;17:163–73.
Schwartz JB, Simonell AP, Higuchi WI. Drug release from wax matrices: analysis of data with first-order kinetics and with the diffusion-controlled model. J Pharm Sci 1968;57:274–7.
Higuchi T. Mechanism of sustained-action medication. Theoretical analysis of rate of release of solid drugs dispersed in solid matrices. J Pharm Sci 1963;52:1145–9.
Korsmeyer RW, Gurny R, Doelker E, Buri P, Peppas NA. Mechanisms of solute release from porous hydrophilic polymers. Int J Pharm 1983;15:25–35.
Peppas NA. Analysis of fickian and non-fickian drug release from polymers. Pharm Acta Helv 1985;60:110–1.
Indian Pharmacopoeia. Govt. of India. Ministry of health and family welfare. Vol. 2. Delhi Pub Microbiol Assays; 1996. p. 100-7.
Satturwar PM, Fulzele SV, Nande VS, Khandare JN. Indian J Pharm Sci 2002;64:155-8.
Van Cutsem J, Van Gerven F, Van de Ven MA, Borgers M, Janssen PA. Itraconazole, a new triazole that is orally active in aspergillosis. Antimicrob Agents Chemother 1984;26:527–34.
El-Bagory IM, Hosny EA, Al-Suwayeh SA, Mahrous GM, Al-Jenoobi FI. Effects of sphere size, polymer to drug ratio and plasticizer concentration on the release of theophyline from ethylcellulose microspheres. Saudi Pharm J 2007;15:213–7.